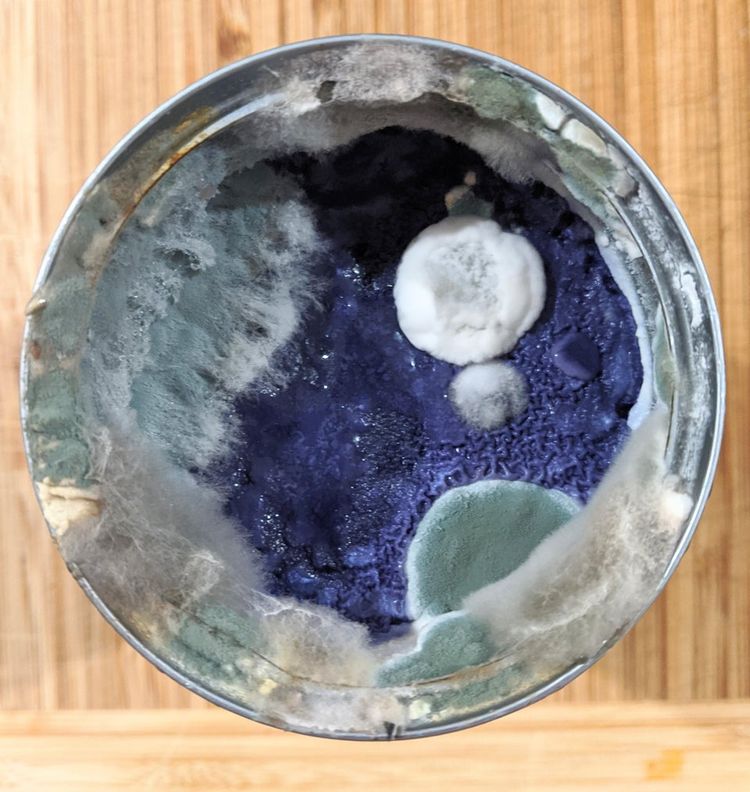
18екн

Когда мы слышим слово «плесень», то нас обычно передёргивает, потому что мы сразу представляем что-то нелицеприятное и, проще говоря, отвратительное. Но даже плесень может быть красивой и сейчас вы в этом убедитесь!
Эти апельсины заплесневели и стали выглядеть как звёзды

Что случится, если забыть борщ на пару дней на плите

"Я приготовил овощное рагу из чечевицы и сильно заболел. Лишь неделю спустя я вспомнил о нём и заглянул под крышку"

Банка с заплесневевшим сахаром, который оставили там на 20 лет. Видимо, в банку попала влага, что привело к такому результату

Кто посеял траву на спагетти?

Так выглядит заплесневевший кофе

Заплесневевший старый стол для настольного футбола, который стал выглядеть как картина

Красивая прическа из плесени на неопознанной еде

Посмотрите на эти очаровательные «жемчужины»

Возможно, это был йогурт или что-то в этом роде, теперь это просто красиво

Плесень, образовавшаяся на салатной заправке с голубым сыром

Колония плесени, выросшая на куске варёной колбасы

Заплесневевшее пюре из тыквы

Интересные образцы плесени на потолке канализационного тоннеля

Эта тыква покрылась плесенью и стала выглядеть ещё более жутко

Кокосовые сливки, о которых очень надолго забыли
Род плесени под названием «волчье молоко»

Заплесневевшие консервированные персики

"Я нашёл это на кухонной стене под потолком и долго не мог понять, что это. Но знающие люди подсказали, что это белая слизистая плесень"

